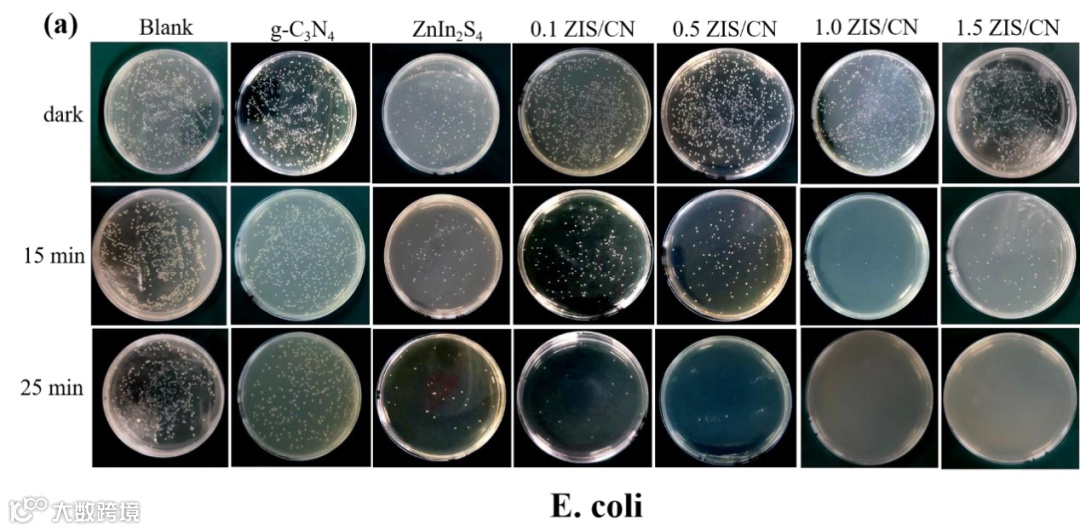
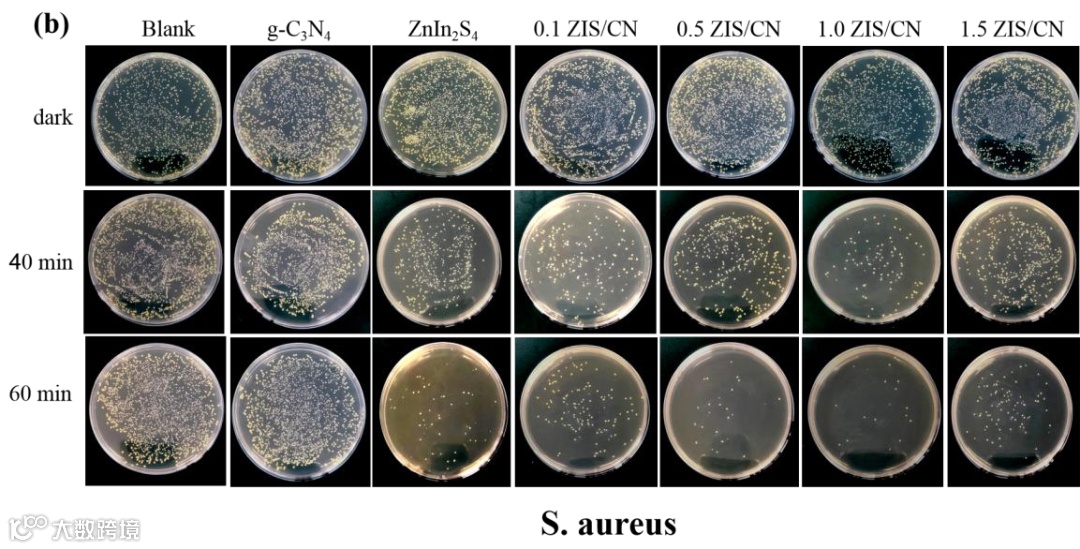

文 章 信 息
研 究 背 景
文 章 简 介

本 文 要 点

文 章 链 接
通 讯 作 者 简 介
课 题 组 介 绍



添加官方微信 进群交流
SCI二氧化碳互助群
SCI催化材料交流群
SCI钠离子电池交流群
SCI离子交换膜经验交流群
SCI燃料电池交流群
SCI超级电容器交流群
SCI水系锌电池交流群
SCI水电解互助群
SCI气体扩散层经验交流群
备注【姓名-机构-研究方向】
投稿请联系contact@scimaterials.cn

点分享

点赞支持

点在看


